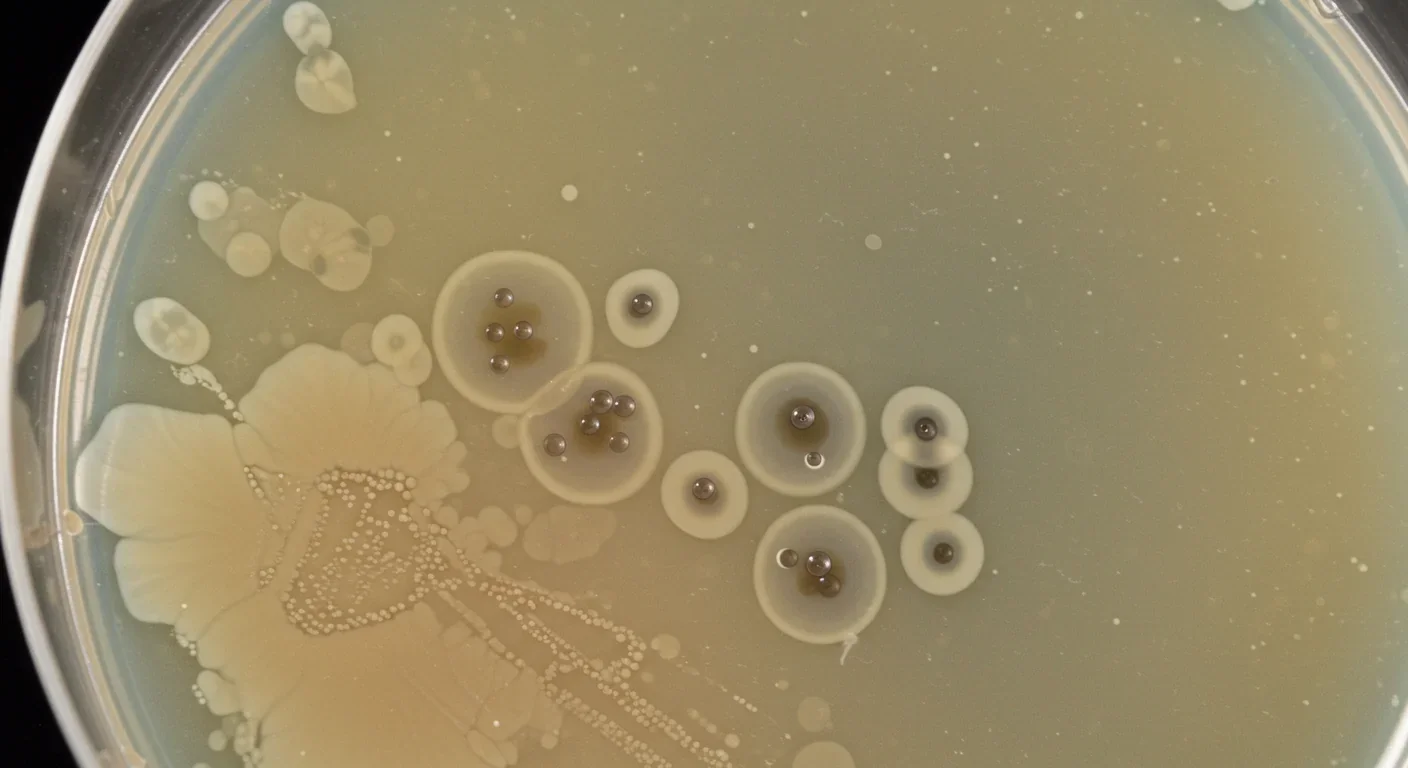
Petri dish showing bacteriophage plaques where viruses killed bacterial colonies

How Gut Bacterium Bt Unlocks Fiber's Hidden Nutrition

TL;DR: Fecal virome transplants harness bacteriophages - viruses that hunt bacteria - to precision-engineer gut health, offering safer alternatives to traditional fecal transplants for treating inflammatory bowel disease, metabolic disorders, and immune conditions.
Your gut is home to trillions of viruses right now, and they're not your enemy - they're running the show. While you've probably heard about the gut microbiome, the bacterial ecosystem that influences everything from digestion to mood, there's an invisible architect orchestrating the whole operation: the virome. These are bacteriophages - viruses that specifically hunt bacteria - and scientists are now learning to harness them as precision medicine. Fecal virome transplants (FVT) represent a radical departure from traditional fecal microbiota transplants, isolating just the viral component and using it to reprogram gut health. The implications could reshape how we treat inflammatory bowel disease, metabolic disorders, and even autoimmune conditions.

The human gut virome is staggeringly abundant, containing 10⁹ to 10¹⁰ viral particles per gram of feces. That's roughly one virus for every ten bacteria, and most of them are bacteriophages - specialized viruses that infect and kill bacteria. Unlike the viruses that cause disease in humans, phages are remarkably specific. Each type of phage targets particular bacterial species, sometimes even specific strains, making them nature's precision weapon.
The discovery of this viral ecosystem has transformed our understanding of gut health. Researchers once thought the microbiome was primarily about bacteria competing for resources and space. Now we know phages are actively sculpting these bacterial communities, determining which species thrive and which get eliminated. This isn't random destruction - it's sophisticated population control.
What makes phages particularly interesting is their dual lifestyle. Some phages are temperate, meaning they integrate their genetic material into bacterial chromosomes and lie dormant. Others are lytic, immediately killing their bacterial hosts and releasing hundreds of new phages. This flexibility allows them to respond dynamically to changes in the gut environment.
Your gut contains up to 10 billion viral particles per gram of feces - roughly one virus for every ten bacteria, working 24/7 to shape your microbial ecosystem.
Recent metagenomic studies have revealed just how personalized the virome is. Your viral profile is as unique as your fingerprint, shaped by diet, geography, medication history, and genetics. The Chinese Gut Virus Catalogue project, analyzing over 15,000 individuals, identified disease-specific viral signatures associated with conditions ranging from colorectal cancer to inflammatory bowel disease.
Fecal microbiota transplantation has been a medical success story, particularly for recurrent Clostridioides difficile infections. The procedure is straightforward: take fecal material from a healthy donor, process it, and transfer it to a patient with dysbiosis (microbial imbalance). Success rates for C. diff exceed 90%, far surpassing antibiotic treatment.
But FMT is essentially a black box. You're transferring an entire ecosystem - bacteria, viruses, fungi, metabolites, and countless uncharacterized molecules. This complexity is both a strength and a weakness. While the whole ecosystem might restore balance, it also introduces risks. Patients have acquired antibiotic-resistant bacteria through FMT. There have been reports of weight gain following transplants from obese donors, suggesting metabolic traits can transfer.
The FDA has tightened screening requirements after several safety incidents, but the fundamental challenge remains: we're transferring living organisms with unpredictable interactions. Donor selection is critical but imperfect. Even extensively screened donors may harbor pathogens that don't cause symptoms in them but could trigger problems in immunocompromised recipients.
Perhaps most importantly, FMT's effectiveness varies wildly outside of C. diff infections. Results for inflammatory bowel disease have been inconsistent, with some patients showing dramatic improvement while others experience no benefit or even worsening symptoms. This unpredictability suggests that transferring everything isn't always the answer - sometimes you need precision.
Fecal virome transplantation takes a radically different approach by isolating just the viral fraction from donor fecal material. The process involves filtering out bacteria and larger particles, leaving primarily bacteriophages and their genetic material. This viral concentrate can then be administered to patients, where phages begin modulating the existing bacterial community.
The safety profile is immediately more attractive. Since you're not transferring living bacteria, you eliminate the risk of transferring antibiotic resistance genes or pathogenic bacteria. Phages can't infect human cells - they lack the molecular machinery to do so. Their targets are exclusively bacterial, and often quite specific.
"By isolating the viral component, we can harness the precision of bacteriophages while eliminating many of the risks associated with whole microbiota transplants. It's like using a scalpel instead of a sledgehammer."
- Microbiome researchers studying FVT applications
Studies in animal models have demonstrated FVT's potential. Research on broiler chickens found that virome transplants significantly improved growth performance and intestinal development. The transplanted phages didn't just randomly attack bacteria; they selectively modulated the bacterial community in ways that enhanced nutrient absorption and reduced inflammation.
In mice, researchers discovered that virome transplants from lean donors could reduce weight gain and improve glucose metabolism in obese recipients. The mechanism appears to involve phages altering the ratio of Firmicutes to Bacteroidetes - two major bacterial phyla with opposite effects on energy harvest. By selectively targeting certain bacteria, phages shifted the balance toward a metabolically healthier profile.
Human trials are beginning to show promise. A preprint study found that carefully prepared virome transplants could be administered without triggering diarrhea when eukaryotic viruses (those that infect human or animal cells) were reduced through specialized culturing techniques. This suggests that refining the viral composition - removing potentially harmful eukaryotic viruses while preserving beneficial bacteriophages - could make FVT both safer and more effective.
Understanding how bacteriophages actually work reveals why they're so powerful as therapeutic agents. Phages are arguably the most abundant biological entities on Earth, and they've been locked in an evolutionary arms race with bacteria for billions of years.

When a phage encounters its bacterial target, it binds to specific receptors on the bacterial cell surface - think of it as a molecular lock and key. Once attached, the phage injects its genetic material into the bacterial cell. What happens next depends on the phage's strategy.
Lytic phages are the terminators of the viral world. They hijack the bacterial cell's machinery to manufacture hundreds of new phages, then burst the cell open in a process called lysis. A single phage can produce 50-200 offspring, which then go on to infect neighboring bacteria. This exponential growth means a small dose of phages can rapidly expand to therapeutic levels.
Temperate phages play a longer game. They integrate their DNA into the bacterial chromosome and replicate quietly alongside the bacterium for generations. This sounds benign, but it gives phages remarkable power. They can carry genes that alter bacterial behavior - including genes for antibiotic resistance, virulence factors, or metabolic capabilities.
The evolutionary pressure is intense. Bacteria develop resistance mechanisms: modifying their surface receptors so phages can't bind, developing CRISPR-like immune systems that recognize and destroy phage DNA, or producing proteins that interfere with phage replication. In response, phages evolve new binding strategies, anti-CRISPR proteins, and increasingly sophisticated ways to hijack bacterial machinery.
This co-evolutionary dance has profound implications for the gut. Phages shape bacterial diversity not just through predation but by moving genes between bacterial species through a process called horizontal gene transfer. A phage that infects one bacterial species can pick up genes and deliver them to another, rapidly spreading beneficial or harmful traits through the community.
Bacteriophages have been locked in an evolutionary arms race with bacteria for billions of years, making them nature's most sophisticated bacterial hunters - and our potential allies in precision medicine.
Recent research has revealed that phages encode metabolic functions directly. Some phages carry genes for carbohydrate metabolism, allowing infected bacteria to process nutrients they couldn't handle before. Others encode proteins that help bacteria tolerate stress or evade immune detection. This means phages aren't just killing bacteria - they're actively reprogramming them.
The relationship between gut viruses and the immune system is turning out to be far more sophisticated than anyone imagined. Your immune system is constantly monitoring the gut for threats, and phages are right in the middle of that conversation.
Phage particles themselves can interact with immune cells. Research has shown that bacteriophages can bind to immune cell receptors and trigger inflammatory or anti-inflammatory responses depending on context. Some phages display molecular patterns that resemble bacterial components, essentially teaching the immune system what to look for. Others appear to suppress excessive inflammation, potentially acting as immune modulators.
In inflammatory bowel disease, the virome shows distinct abnormalities. Studies consistently find that IBD patients have altered phage communities, with increased abundance of certain bacteriophages but decreased viral diversity. This phage dysbiosis correlates with disease severity and appears to contribute to chronic inflammation.

The mechanism involves phages influencing which bacteria colonize the gut lining. Certain bacteria produce metabolites that either strengthen or weaken the intestinal barrier. By selectively targeting specific bacterial strains, phages can shift the metabolite profile, affecting barrier integrity. A leaky gut allows bacterial components to enter tissues, triggering immune responses that perpetuate inflammation.
Even more intriguing is emerging evidence linking gut viruses to central nervous system disorders. The gut-brain axis - the bidirectional communication between the digestive system and brain - appears to include a viral component. Phages that alter bacterial populations can change the production of neurotransmitter precursors, potentially affecting mood, cognition, and neuroinflammation.
Autoimmune connections are also emerging. Research has identified a specific bacteriophage whose protein mimics human autoantigens, potentially triggering Sjögren's disease. This molecular mimicry - where viral proteins resemble human proteins - could explain how gut viral changes contribute to systemic autoimmune conditions.
Translating virome science into clinical treatments is happening faster than many expected. Several research groups are moving from animal models to human trials, with some encouraging early results.
For inflammatory bowel disease, the rationale for FVT is compelling. Since phage dysbiosis is clearly linked to IBD, restoring a healthy virome could address underlying causes rather than just suppressing symptoms. Traditional IBD treatments - immunosuppressants and biologics - work by dampening inflammation, but they don't fix the microbial imbalance. FVT offers the possibility of resetting the ecosystem.
"The potential to address root causes of IBD rather than merely managing symptoms represents a paradigm shift in how we approach chronic inflammatory conditions."
- Gastroenterology researchers
Small pilot studies are underway testing FVT for ulcerative colitis and Crohn's disease. The approach typically involves screening healthy donors, isolating their viral fraction, and administering it to patients through colonoscopy or oral capsules. Early reports suggest the procedure is well-tolerated, though efficacy data remains preliminary.
Metabolic disorders represent another promising application. Since virome composition affects energy harvest from food, there's potential to treat obesity and type 2 diabetes by modulating gut bacteria through phages. The advantage over traditional FMT is precision - you could theoretically design virome cocktails that specifically target bacteria associated with metabolic dysfunction.
Cancer therapy is an unexpected frontier. Recent research found that virome dysbiosis impairs response to chemotherapy in colorectal cancer patients. Tumors rely on the local microbial environment, and certain bacteria can make tumors more resistant to treatment. Phages that eliminate these protective bacteria could enhance chemotherapy effectiveness.

Antibiotic resistance is perhaps the most urgent application. As traditional antibiotics become less effective, phages offer an alternative that bacteria struggle to evade. Unlike antibiotics that target broad categories of bacteria, phages can be precisely targeted to kill specific pathogens while leaving beneficial bacteria untouched. Several clinical trials are testing phage therapy for multidrug-resistant infections.
The technology for customizing phage cocktails is advancing rapidly. Single-virus genomics allows researchers to identify and characterize individual phages from complex mixtures, even uncultured ones. This means you could sequence a patient's virome, identify which phages are missing or overabundant, and design a personalized viral transplant to restore balance.
Despite the promise, FVT isn't risk-free. The biggest concern is unintended consequences. Introducing new phages into a gut ecosystem is inherently unpredictable. Phages might target beneficial bacteria along with harmful ones, or they might transfer genes in unexpected ways.
Eukaryotic viruses present a particular concern. While bacteriophages can't infect human cells, donor fecal material also contains viruses that target human and animal cells. Some of these, like cytomegalovirus (CMV), can modulate intestinal epithelial function through interferon signaling. In healthy people this might be neutral or even beneficial, but in immunocompromised patients it could trigger serious illness.
The solution appears to be better purification techniques. Chemostat culturing - growing donor microbes in controlled conditions before extracting phages - can significantly reduce eukaryotic viral load while preserving bacteriophages. This creates a safer viral preparation, though it adds complexity and cost.
Phage resistance is inevitable. Bacteria will evolve countermeasures to any phages we introduce, potentially faster than with antibiotics since the evolutionary arms race between phages and bacteria has been ongoing for eons. The advantage is that phages co-evolve with bacteria, so natural viral communities include diverse phages that overcome resistance.
While FVT shows tremendous promise, questions remain about long-term effects, phage persistence in the gut, and optimal treatment protocols - areas where ongoing clinical trials will provide critical answers.
Long-term effects remain unknown. Will transplanted phages persist in the gut, or will they be outcompeted by native viruses? How often would treatments need to be repeated? Could repeated virome transplants eventually destabilize the ecosystem rather than restoring it?
Regulatory pathways are still being established. The FDA is developing frameworks for approving phage therapies, but FVT sits in a gray zone between drugs, biologics, and tissue transplants. Each regulatory category has different requirements, and it's unclear which applies to viral preparations.
The future of FVT likely isn't one-size-fits-all transplants but precision virome engineering. Imagine a diagnostic that sequences your gut virome and bacterial microbiome, identifies specific imbalances, and prescribes a custom phage cocktail targeting exactly the bacteria causing problems.
This is becoming technically feasible. Metagenomic sequencing can now map entire viral communities in days, identifying thousands of phages and their bacterial targets. Machine learning algorithms can predict which phages will be most effective for a given bacterial profile. Synthetic biology tools allow researchers to modify phages, enhancing their targeting specificity or adding new functions.
Some research groups are building standardized phage libraries - collections of characterized bacteriophages with known targets and safety profiles. Instead of using whole donor viromes, clinicians could select specific phages from these libraries to construct rational therapeutic cocktails. This would be analogous to how antibiotics are prescribed based on bacterial culture results, except far more precise.
The infrastructure is slowly developing. Stool banks that currently store fecal material for FMT could expand to bank viral fractions. Quality control standards, screening protocols, and preparation methods are being standardized across research institutions. Clinical trial networks focused on microbiome therapies are incorporating virome studies.
Economic factors will influence adoption. FVT could be significantly cheaper than traditional FMT if it eliminates the need for extensive donor screening and reduces adverse events. But if personalized phage cocktails require whole-genome sequencing and custom preparation, costs could escalate beyond what many healthcare systems can afford.
Public perception matters too. Getting people comfortable with intentional virus transplants - even beneficial viruses - requires education and trust. The term "virome" itself is still unfamiliar to most people, and overcoming the instinctive negative association with "virus" will take time.
Within the next decade, it's plausible that virome analysis will become part of routine health assessments, particularly for people with digestive or immune disorders. Your doctor might order a gut viral profile alongside standard blood work, looking for signatures that predict disease risk or explain chronic symptoms.
For patients currently struggling with conditions like IBD, recurrent C. diff, or metabolic syndrome, FVT could offer an option when standard treatments fail. It won't be a miracle cure - gut health is too complex for simple fixes - but it might provide significant symptom relief and reduce dependence on immunosuppressive drugs.
The biggest shift might be conceptual. We're moving from fighting viruses to collaborating with them, recognizing that our bodies are ecosystems requiring balance rather than sterility. The virome isn't an invader to be eliminated but a partner to be understood and, when necessary, recalibrated.
Research into precision microbiome medicine is accelerating. Every month brings new discoveries about phage-bacteria-immune interactions, disease-associated viral signatures, and therapeutic strategies. The Chinese Gut Virus Catalogue is just the beginning - similar large-scale virome mapping projects are underway globally.
This is part of a broader transformation in medicine toward treating patients as complex systems rather than collections of organs and symptoms. The human body hosts trillions of microorganisms, and maintaining their balance is fundamental to health. Virome transplants represent one tool in what will eventually be a comprehensive toolkit for managing these microbial partnerships.
The promise isn't just treating existing disease but potentially preventing it. If we can identify viral signatures that precede inflammatory bowel disease, metabolic disorders, or autoimmune conditions, we could intervene before symptoms develop. Preventive virome modulation could become part of maintaining health, not just restoring it.
We're in the early stages of understanding how the invisible viral world shapes human biology. The gut virome is vast, personalized, and dynamic - qualities that make it challenging to study but also tremendously powerful as a therapeutic target. As sequencing technology improves, computational models become more sophisticated, and clinical trials accumulate data, fecal virome transplants could transition from experimental curiosity to standard medical practice.
The next frontier in medicine isn't fighting every microbe but learning which ones to nurture, which ones to eliminate, and how viruses can help us make those distinctions. Your gut's viral community has been quietly managing your bacterial populations your entire life. Now we're learning to work with them deliberately, harnessing evolution's oldest predator-prey relationship to restore health from the inside out.

Saturn's moon Titan may harbour liquid water beneath its frozen crust, kept from freezing by ammonia acting as a natural antifreeze. New Cassini data suggests the interior could be slush with warm water pockets rather than a global ocean, and NASA's Dragonfly mission launching in 2028 aims to investigate whether this exotic environment could support life.

Bacteroides thetaiotaomicron uses 88 specialized gene clusters and over 260 enzymes to decode and digest dietary fibers humans can't break down, converting them into essential short-chain fatty acids. When fiber runs out, it eats your gut's protective mucus instead, with cascading health consequences.

Scientists are restoring Ice Age ecological dynamics through rewilding projects like Siberia's Pleistocene Park and de-extinction efforts by Colossal Biosciences. These initiatives aim to reintroduce megafauna or their proxies to repair broken ecosystems, protect Arctic permafrost, and slow climate change.

The cheerleader effect is a proven cognitive bias where people look more attractive in groups because the brain automatically averages faces, smoothing out individual flaws. Research shows the sweet spot is 3-5 people, it works for all genders, and it has real implications for dating apps and social media strategy.

The Hawaiian bobtail squid farms bioluminescent bacteria in a specialized light organ to erase its shadow in moonlit waters. This partnership, where bacteria reshape the squid's body and communicate through quorum sensing, is teaching scientists how host-microbe relationships work and inspiring new medical and biotech applications.

Millions are leaving social media platforms driven by privacy scandals, mental health concerns, and algorithmic manipulation. While 60% relapse within a week, those who stay away report dramatically improved wellbeing, and decentralized alternatives like Bluesky are surging.

Building a reliable quantum computer requires roughly 1,000 fragile physical qubits per logical qubit due to surface code error correction overhead. New code families like LDPC and neutral-atom platforms are racing to slash that ratio, with some teams claiming it could drop to as few as 5-to-1.